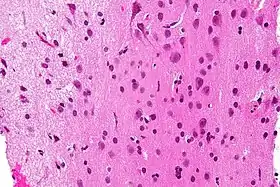

المادة البيضاء
المادة البيضاء هي أحد المادتين المكونتين للجهاز العصبي المركزي (حيث تكون المادة الرمادية هي المكون الثاني) تتكون بشكل أساسي من خلايا دبقية ومحاور عصبية مغمدة بغمد الميالين (النخاعين).[1][2][3]
| المادة البيضاء | |
|---|---|
| الاسم اللاتيني substantia alba | |
![]() صورة مجهرية تظهر المادة البيضاء بمظهرها المميز الشبيه بالشبكة (إلى يسار الصورة - الظل الأفتح لللون الوردي) والمادة الرمادية بأجسام خلاياها العصبونية (إلى يمين الصورة - الظل الغامق لللون الوردي). صبغة HPS. | |
![]() الدماغ البشري مشرحا جانبيا وتظهر المادة الرمادية(الأجزاء الخارجية ذات اللون الأغمق), والمادة البيضاء (الأجزاء الداخلية والأكثر بياضا بشكل واضح). الدماغ البشري مشرحا جانبيا وتظهر المادة الرمادية(الأجزاء الخارجية ذات اللون الأغمق), والمادة البيضاء (الأجزاء الداخلية والأكثر بياضا بشكل واضح). | |
| تفاصيل | |
| جزء من | دماغ |
| ترمينولوجيا أناتوميكا | 14.1.00.009، A14.1.02.024، A14.1.02.201، A14.1.04.101، A14.1.05.102، A14.1.05.302 و A14.1.06.201 |
| FMA | 83929 |
| UBERON ID | 0002316 |
| ن.ف.م.ط. | A08.186.211.204، وA08.186.854.880 |
| ن.ف.م.ط. | D066127 |
| دورلاند/إلزيفير | White matter |

بنية المادة البيضاء لدماغ الإنسان (مأخوذة بوساطة التصوير بالرنين المغناطيسي).
روابط خارجية
- White Matter Atlas
- WebMD (2009). "white matter". Webster's New World Medical Dictionary (الطبعة 3rd). Houghton Mifflin Harcourt. صفحة 456. ISBN 978-0-544-18897-6. الوسيط
|CitationClass=تم تجاهله (مساعدة)
مراجع
- Douglas Fields, R. (2008). "White Matter Matters". Scientific American. 298 (3): 54–61. Bibcode:2008SciAm.298c..54D. doi:10.1038/scientificamerican0308-54. الوسيط
|CitationClass=تم تجاهله (مساعدة) - Leenders, K. L.; Perani, D.; Lammertsma, A. A.; Heather, J. D.; Buckingham, P.; Jones, T.; Healy, M. J. R.; Gibbs, J. M.; Wise, R. J. S.; Hatazawa, J.; Herold, S.; Beaney, R. P.; Brooks, D. J.; Spinks, T.; Rhodes, C.; Frackowiak, R. S. J. (1990). "Cerebral Blood Flow, Blood Volume and Oxygen Utilization". Brain. 113: 27–47. doi:10.1093/brain/113.1.27. PMID 2302536. الوسيط
|CitationClass=تم تجاهله (مساعدة) - Alfonso-Loeches, Silvia; Pascual, Maria; Gómez-Pinedo, Ulises; Pascual-Lucas, Maya; Renau-Piqueras, Jaime; Guerri, Consuelo (2012). "Toll-like receptor 4 participates in the myelin disruptions associated with chronic alcohol abuse". Glia. 60 (6): 948–64. doi:10.1002/glia.22327. PMID 22431236. الوسيط
|CitationClass=تم تجاهله (مساعدة)
- بوابة علوم عصبية
- بوابة تشريح
في كومنز صور وملفات عن: المادة البيضاء
This article is issued from Wikipedia. The text is licensed under Creative Commons - Attribution - Sharealike. Additional terms may apply for the media files.